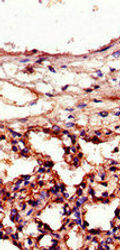
ICAM1 Antibody

ICAM1 Antibody
Shipping Cost Note
Each Antibody price includes shipping cost to Canada and import fees. Please ask for a discounted quote if ordering multiple antibodies.
Delivery Time Note
This product is usually imported from the manufacturer after order placement. Please expect longer delivery times of 7-14 days.
Catalog no.
CSB-PA07149A0Rb
Name
ICAM1 Antibody
Aliases
Antigen identified by monoclonal BB2; BB 2; BB2; CD 54; CD_antigen=CD54; CD54; Cell surface glycoprotein P3.58; Human rhinovirus receptor; ICAM 1; ICAM-1; ICAM1; ICAM1_HUMAN; intercellular adhesion molecule 1 (CD54); intercellular adhesion molecule 1 (CD54), human rhinovirus receptor; Intercellular adhesion molecule 1; Major group rhinovirus receptor; MALA 2; MALA2; MyD 10; MyD10; P3.58; Surface antigen of activated B cells; Surface antigen of activated B cells, BB2
CloneID
N/A
Antibody Type
Polyclonal Antibody
Antigen Species
Human
Uniprot ID
P05362
Antigen
Recombinant Human Intercellular adhesion molecule 1 protein (320-480AA)
Host Species
Rabbit
Species Reactivity
Human, Rat
Tested Applications
ELISA, WB, IHC, IF; Recommended dilution: WB:1:200-1:5000, IHC:1:20-1:200, IF:1:50-1:200
Clonality
Polyclonal
Isotype
IgG
Purification
>95%, Protein G purified
Conjugate
Non-conjugated
Buffer
0.03% Proclin 300, 50% glycerol, 0.01M PBS, pH 7.4.
Form
Liquid
Storage
Upon receipt, store at -20°C or -80°C. Avoid repeated freeze.
Target Name
ICAM1
Research Area
Immunology
Additional Product Information